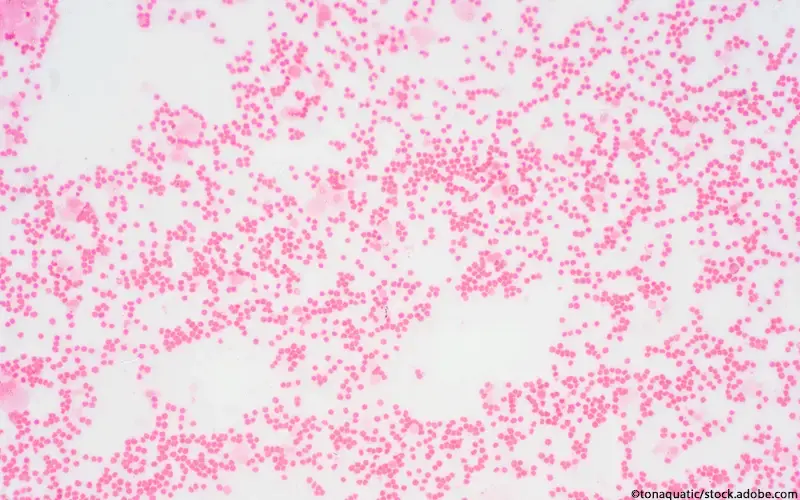
Myelofibrose

Neue Medikamente
Aktuelle Informationen zu neuen Medikamenten und Wirkstoffen, die nach behördlicher Neuzulassung von Pharma-Herstellern in den deutschen Markt eingeführt wurden. Hier informieren wir medizinische Fachkreise über Anwendung, Wirkung und Besonderheiten der neuen Arzneimittel und Wirkstoffe.